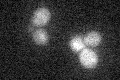
YIL056W
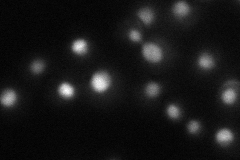
YIL056W
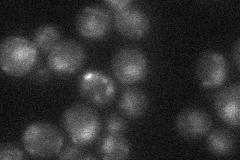
YIL056W
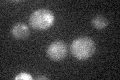
YIL056W

View description
Transcriptional activator, required for the vitamin H-responsive element (VHRE) mediated induction of VHT1 (Vitamin H transporter) and BIO5 (biotin biosynthesis intermediate transporter) in response to low biotin concentrations
Localization:
Intensity:
Fold change:
Significance:
-
C’ GFP library in SD
below threshold16.32 -
N' NOP1pr-GFP in SD

punctate,nucleus51.6521 -
N' TEF2pr-mCherry in SD
nucleus30.8558 -
N' NATIVEpr-GFP in SD
nucleus22.796 -
N' TEF2pr-VC and Cyto-VN in SD

#N/A0 -
C’ GFP library in SD+DTT

cytosol18.31.12No -
C’ GFP library in SD+H2O2

cytosol19.51.19No -
C’ GFP library in Starvation Media
cytosol17.841.09No -
C’ GFP library on the background of Pup2-DaMP

below threshold -
C’ GFP library on the background of CCT mutant

below threshold18.10461.10839No
